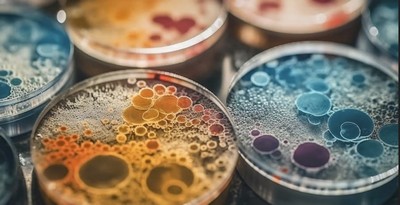

Quand la glace fond, elle libère des microbes du passé. Certains de ces microbes, voyageurs du temps, sont capables de survivre et même de s’épanouir dans notre environnement. Avec des effets qui restent imprévisibles. Et c’est ce qui inquiète le plus les chercheurs.
Plusieurs études ont déjà porté sur le sujet. Des microbes piégés depuis longtemps dans les glaces pourraient être libérés à la faveur du réchauffement climatique et de la fonte (...)
Les chercheurs ont imaginé des scénarios dans lesquels des agents pathogènespathogènes, comme des sortes de virus numériques, surgissent du passé pour envahir des communautés bactériennes virtuelles, mais qui ressemblent à celle que l’on en trouve de nos jours dans la nature. Et ils ont laissé leurs expériences d’évolution artificielle montrer les effets de ces attaques sur la diversité des bactériesbactéries. En fonction de variables modifiées à leur guise. Le tout, sans avoir à manipuler de vrais agents pathogènes.
Les simulations informatiques menées par les chercheurs montrent d’abord que les microbes du passé sont capables de survivre et de se développer dans les communautés bactériennes modernes. À tel point que 3 % de ces agents pathogènes sont même devenus dominants. La plupart, toutefois, sans avoir d’effet que les bactéries. Mais 1 % des microbes, tout de même, a provoqué des effets imprévisibles. Certains ont fait disparaître le tiers des communautés de bactéries. D’autres ont fait augmenter leur diversité de plus de 10 %. Sans que les chercheurs ne comprennent pour quelle raison. (...)
Un faible pourcentage de microbes dangereux dans les glaces, mais un nombre non négligeable (...)
